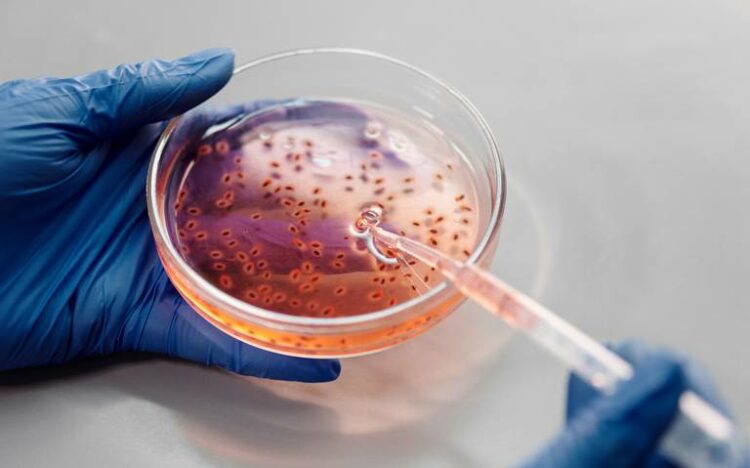
Aumentan a tres las muertes por meningitis en EEUU relacionadas con brote en Tamaulipas

El brote de meningitis surgido en dos clínicas privadas de Matamoros, Tamaulipas, ha llevado a la muerte de tres personas en Estados Unidos, según la CDC (Centros para el Control y la Prevención de Enfermedades). El titular de la Secretaría de Salud, Vicente Joel Hernández Navarro, confirmó a EL SOL DE TAMPICO que se han reportado tres fallecimientos en Estados Unidos.
El brote de meningitis fue anunciado por el Departamento de Salud de Texas el martes 16 de mayo, indicando inicialmente una muerte y cuatro personas hospitalizadas por posible infección, todas ellas tras haberse sometido a procedimientos médicos en las mencionadas clínicas de Matamoros.
En respuesta al brote, el Gobierno de Tamaulipas ha anunciado que presentará una denuncia contra quienes resulten responsables.
La Secretaría de Salud de Tamaulipas informó que, desde que se detectó el brote, 55 personas han sido evaluadas por resultar positivas, probables o sospechosas de estar infectadas por el hongo Fusarium Solani, que produce esta forma de meningitis.
«Tenemos un total de 55 entre sospechosos, probables y confirmados; en México cinco sospechosos, en Estados Unidos 14. Probables en México 17 y en Estados Unidos 11; confirmados son seis en México y dos en Estados Unidos”, explicó Hernández Navarro.
Además, nueve personas están hospitalizadas en México, repartidas entre la Secretaría de Salud, el Instituto Mexicano del Seguro Social (IMSS) y un hospital privado.
Hernández Navarro destacó que todas las pacientes afectadas por este brote son mujeres. “Todas son mujeres de lo que llevamos, posibles sospechosas por haberse realizado una cirugía de bloqueo”, declaró. La mayoría de las cirugías realizadas en estas clínicas corresponden a procedimientos estéticos, incluyendo aumento de busto, glúteos, liposucción y otros procedimientos como levantamiento de glúteos brasileño e implantes.
Este brote y las consecuentes muertes en Estados Unidos han impulsado una respuesta binacional a la emergencia de salud.
Descubre más desde Cronista
Suscríbete y recibe las últimas entradas en tu correo electrónico.